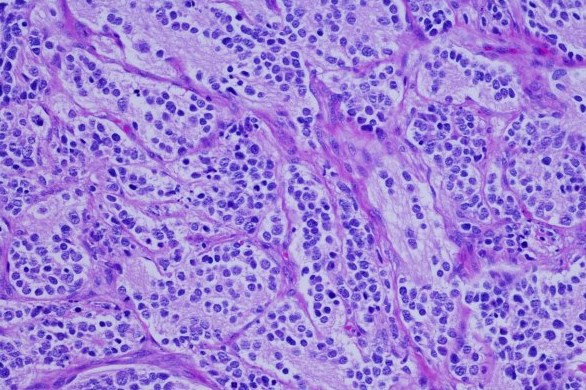
Australia thử nghiệm thuốc mới hỗ trợ điều trị ung thư tuyến tụy

BNEWS Các nhà nghiên cứu quốc tế vừa phát hiện một nhóm tế bào miễn dịch mới mà họ tin rằng rất quan trọng trong việc giúp cơ thể chống lại các bệnh viêm nhiễm nặng và ung thư.
Kết quả nghiên cứu được công bố trên tạp chí Nature ngày 18/8.
Nghiên cứu mới do nhóm nhà khoa học thuộc Viện Miễn dịch và Các bệnh truyền nhiễm Peter Doherty (Australia) phối hợp với một số nhà nghiên cứu thuộc Đại học Kỹ thuật Munich (TUM - Đức).
Giáo sư nghiên cứu miễn dịch học Axel Kallies thuộc Viện Peter Doherty cho biết những bệnh nguy hiểm như ung thư, hoặc các bệnh lây nhiễm do virus, có thể gây ra “sự cạn kiệt miễn dịch” ảnh hưởng đến một loại tế bào miễn dịch được gọi là tế bào T.
Trong các nghiên cứu trước đây, nhóm nghiên cứu của ông Kallies cho thấy không phải tất cả các tế bào T khi chống lại các bệnh mãn tính đều bị cạn kiệt và mất chức năng. Các tế bào gọi là Tpex có thể duy trì chức năng trong một thời gian dài.
Nghiên cứu mới xác định rõ tập hợp con tế bào Tpex có chức năng giống như tế bào gốc, theo đó có vai trò thiết yếu trong việc ngăn chặn sự cạn kiệt tế bào và duy trì các phản ứng lâu dài của tế bào T đối với bệnh nhiễm virus mãn tính.
Tiến sĩ Lorenz Kretschmer thuộc TUM và là tác giả chính của nghiên cứu nhấn mạnh: “Những tế bào này kéo dài khả năng miễn dịch của tế bào T, cho phép các tế bào T đã cạn kiệt tự tái tạo và duy trì chức năng”.
Phát hiện trên giúp giải thích tại sao liệu pháp miễn dịch không hiệu quả đối với một số bệnh nhân, và có thể dẫn đến sự phát triển các liệu pháp mới hiệu quả hơn để điều trị ung thư và các bệnh nhiễm virus như bệnh viêm gan và HIV./.
Tin liên quan
Australia thử nghiệm thuốc mới hỗ trợ điều trị ung thư tuyến tụy
Các bác sĩ Australia đang chuẩn bị sử dụng một loại thuốc mới được phát triển như một phần của thử nghiệm lâm sàng cho các bệnh nhân mắc ung thư tuyến tụy.
Tin cùng chuyên mục
-
![]() Kinh tế xã hội
Kinh tế xã hội"Kiềng 3 chân" cho chuyển đổi xanh
Chuyển đổi xanh ở Việt Nam đang được chú trọng với sự tham gia của Nhà nước - doanh nghiệp - người dân để tạo thế "kiềng 3 chân" vững chắc.
-
![]() Kinh tế xã hội
Kinh tế xã hộiLịch thi đấu World Cup 2026 hôm nay ngày 3/7
Vòng đấu loại trực tiếp FIFA World Cup 2026 tiếp tục diễn ra đầy hấp dẫn trong ngày 4/7 (giờ Việt Nam) với ba cặp đấu đáng chú ý.
-
![]() Kinh tế xã hội
Kinh tế xã hộiLịch thi đấu bóng đá hôm nay ngày 3/7/2026
Bnews. Lịch thi đấu bóng đá hôm nay 3/7, sáng mai 4/7 các trận đấu trong nước, quốc tế đêm nay và sáng mai được cập nhật mới nhất, chính xác nhất. Lịch thi đấu ngoại hạng Anh, La Liga, Bundesliga.
-
![]() Kinh tế xã hội
Kinh tế xã hộiXSMB 3/7. Kết quả xổ số miền Bắc hôm nay ngày 3/7/2026. XSMB thứ Năm ngày 3/7
Bnews. XSMB 3/7. Kết quả xổ số hôm nay ngày 3/7. XSMB thứ Năm. Trực tiếp KQXSMB ngày 3/7. Kết quả xổ số miền Bắc hôm nay thứ Năm ngày 3/7/2026.
-
![]() Kinh tế xã hội
Kinh tế xã hộiXSMT 3/7. Kết quả xổ số miền Trung hôm nay ngày 3/7/2026. XSMT thứ Sáu ngày 3/7
Bnews. XSMT 3/7. Kết quả xổ số hôm nay ngày 3/7. XSMT thứ Sáu. Trực tiếp KQXSMT ngày 3/7. Kết quả xổ số miền Trung hôm nay thứ Sáu ngày 3/7/2026.
-
![]() Kinh tế xã hội
Kinh tế xã hộiXSMN 3/7. Kết quả xổ số miền Nam hôm nay ngày 3/7/2026. XSMN thứ Sáu ngày 3/7
XSMN 3/7. KQXSMN 3/7/2026. Kết quả xổ số hôm nay ngày 3/7. XSMN thứ Sáu. Xổ số miền Nam hôm nay 3/7/2026. Trực tiếp KQXSMN ngày 3/7. Kết quả xổ số miền Nam hôm nay thứ Sáu ngày 3/7/2026.
-
![]() Kinh tế xã hội
Kinh tế xã hộiKết quả Vietlott Mega 6/45 ngày 3/7 - Kết quả xổ số Vietlott Mega - Kết quả xổ số Vietlott ngày 3/7/2026
Bnews. Kết quả Vietlott Mega 6/45 ngày 3/7. Kết quả xổ số Vietlott hôm nay ngày 3 tháng 7 năm 2026 - Xổ số Vietlott Mega 6/45 hôm nay.
-
![]() Kinh tế xã hội
Kinh tế xã hộiXSTV 3/7 - Kết quả Xổ số Trà Vinh hôm nay 3/7/2026 - KQXSTV 3/7
Bnews. XSTV 3/7. Kết quả xổ số hôm nay ngày 3/7. XSTV Thứ Sáu. Trực tiếp KQXSTV ngày 3/7. Kết quả xổ số Trà Vinh hôm nay ngày 3/7/2026. Kết quả xổ số Trà Vinh Thứ Sáu ngày 3/7/2026.
-
![]() Kinh tế xã hội
Kinh tế xã hộiXSVL 3/7. Kết quả xổ số Vĩnh Long hôm nay ngày 3/7/2026. SXVL ngày 3/7
Bnews. XSVL 3/7. Kết quả xổ số hôm nay ngày 3/7. XSVL thứ Sáu. Trực tiếp KQXSVL ngày 3/7. Kết quả xổ số Vĩnh Long hôm nay ngày 3/7/2026.













